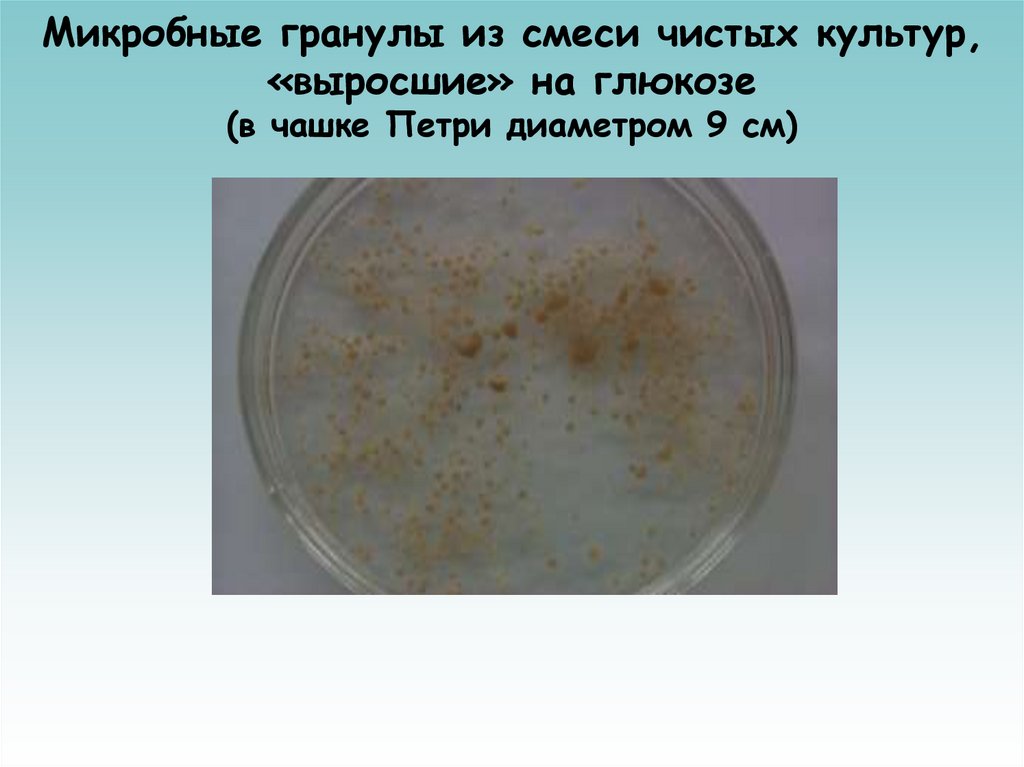
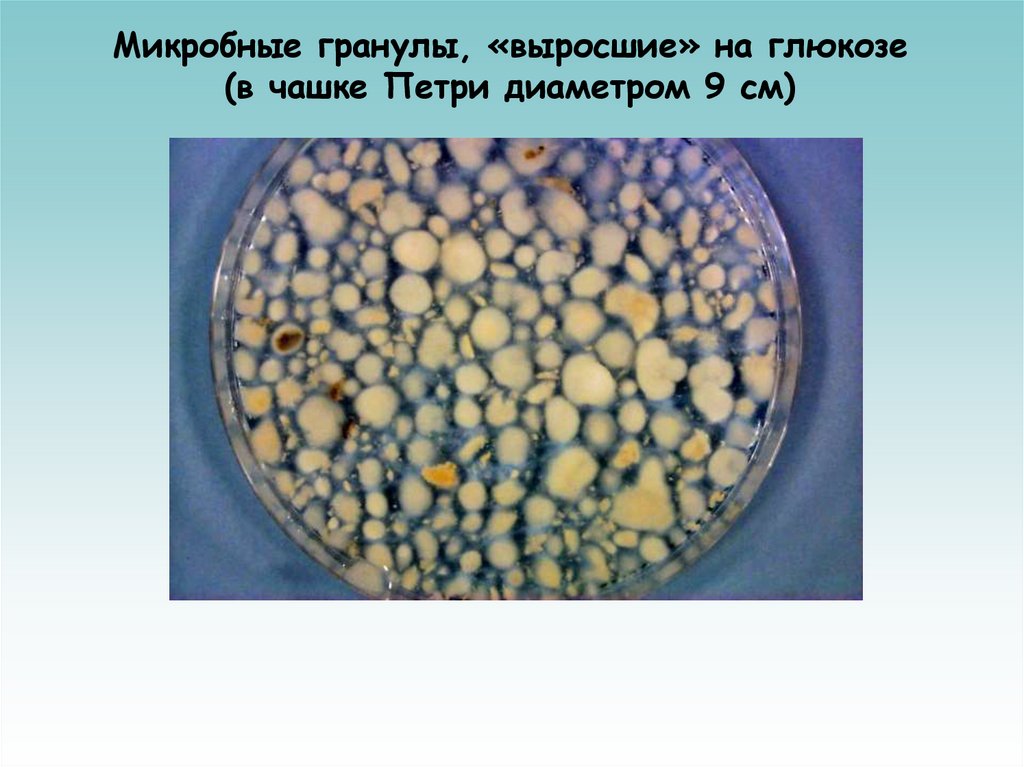

Similar presentations:
Биофабрики вокруг нас
1.
Сироткин А.С., профессор, доктор технических наукКазанский национальный исследовательский
технологический университет
кафедра промышленной биотехнологии
Биофабрики вокруг нас
2.
Процессы самоочищения водоемови технологии биологической очистки сточных вод
Mudrack,K. und
Kunst, S., 1994
3.
Окисление органического вещества бактериями(питание бактерий)
Инфузории-оперкулярии в воде
4.
Сообщество микроорганизмов – активный ил5.
Микробные гранулы из смеси чистых культур,«выросшие» на глюкозе
(в чашке Петри диаметром 9 см)
6.
Изображение края среза гранул толщиной20 мкм из смеси чистых культур
микроорганизмов
а
б
а – на второй; б – на третьей неделе эксперимента:
клетки нитчатых бактерий (синий сигнал);
клетки слизеобразующих бактерий (красный сигнал)
7.
Микробные гранулы, «выросшие» на глюкозе(в чашке Петри диаметром 9 см)
8.
Биопленка на поверхности золы(увеличение х100)
Время культивирования – от 2 до 3 недель
Толщина биопленки - от 0,016 до 0,08 мм
9. О биопленках
- Пленки на поверхности- Хлопья («плавающие биопленки»)
- Маты и илы («толстые биопленки»)
Биопленки –
способ существования 9599% микроорганизмов в природных системах
10. Пористая структура древесного активированного угля (увеличение х500)
11. Микробные клетки на поверхности активированного угля (увеличение х 6750)
12.
Фотографии образцов биопленки избиофильтров
DAPI - окрашенные клетки
FISH протеобактерий бета-группы
(генный зонд Bet42a,
флуоресцирующее вещество
Fluoreszein (зеленый) и
нитрификаторов Nitrosomonas spp.
(генный зонд Nmo254,
флуоресцирующее вещество
Texas-red (красный)
13. Фотографии образцов биопленки из биофильтров
DAPI - окрашенные клеткиFISH протеобактерий бета-группы
(генный зонд Bet42a,
флуоресцирующее вещество
Fluoreszein (зеленый) и
нитрификаторов Nitrosomonas spp.
(генный зонд Nmo254,
флуоресцирующее вещество
Texas-red (красный)
14. Микробный состав биопленки
15.
Анализ технологических схем биологическойочистки сточных вод больших объемов
16. Биофильтры для глубокой нитрификации и осветления сточной воды
17. Башенные биореакторы
18. BIOHOCH-реактор в разрезе
1-круговой лотокдля очищенной воды
2-зона отстаивания
очищенной воды
3-инжекторы
для подачи воздуха
4 – диффузоры
5-камера успокоения
и дегазации
6-камера аэрации
7-очищенная вода
8-активный ил
19. Инжектор BIOHOCH-реактора
20. Резюме
• Доля организмов в общей массе Земли (живой и неживойприроде вместе) составляет 0,25 %, но роль их в её
преобразовании очень велика
Биофабрики могут использовать ценное сырье и отходы,
а производить разнообразные полезные продукты и
обезвреживать вредные вещества
Внимательный, грамотный и разумный человек может
использовать
естественные (природные) биофабрики,
создавать биотехнологии, чтобы получать нужные ему
продукты и не загрязнять среду своего обитания
Сироткин Александр Семенович,
профессор, д.т.н., декан факультета пищевых технологий
заведующий кафедрой промышленной биотехнологии
www.kstu.ru
asirotkin66@gmail.com
Казанский национальный исследовательский
технологический университет